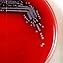

5. Imported Danger
Impossible d'ajouter des articles
Désolé, nous ne sommes pas en mesure d'ajouter l'article car votre panier est déjà plein.
Veuillez réessayer plus tard
Veuillez réessayer plus tard
Échec de l’élimination de la liste d'envies.
Veuillez réessayer plus tard
Impossible de suivre le podcast
Impossible de ne plus suivre le podcast
-
Lu par :
-
De :
À propos de ce contenu audio
A quiet Texas home. A sick raccoon.
A child slipping into intensive care with a disease that should not exist anywhere near the United States.
Within days, three more cases appear across the country — same organism, same clinical chaos, no clear source.
CDC steps in. FBI circles the edge.
Every possibility is ugly, and none of them feel accidental.
What begins as a small household mystery turns into a nationwide hunt for an invisible passenger moving through American homes in plain sight.
Visuals and case-related images for this episode are available on Instagram: @lastdiagnosispodcast
New episode every Thursday.
www.lastdiagnosis.com

Vous êtes membre Amazon Prime ?
Bénéficiez automatiquement de 2 livres audio offerts.Bonne écoute !
Aucun commentaire pour le moment